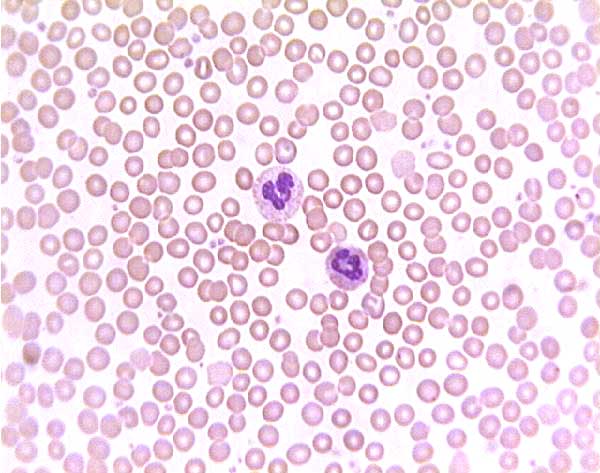
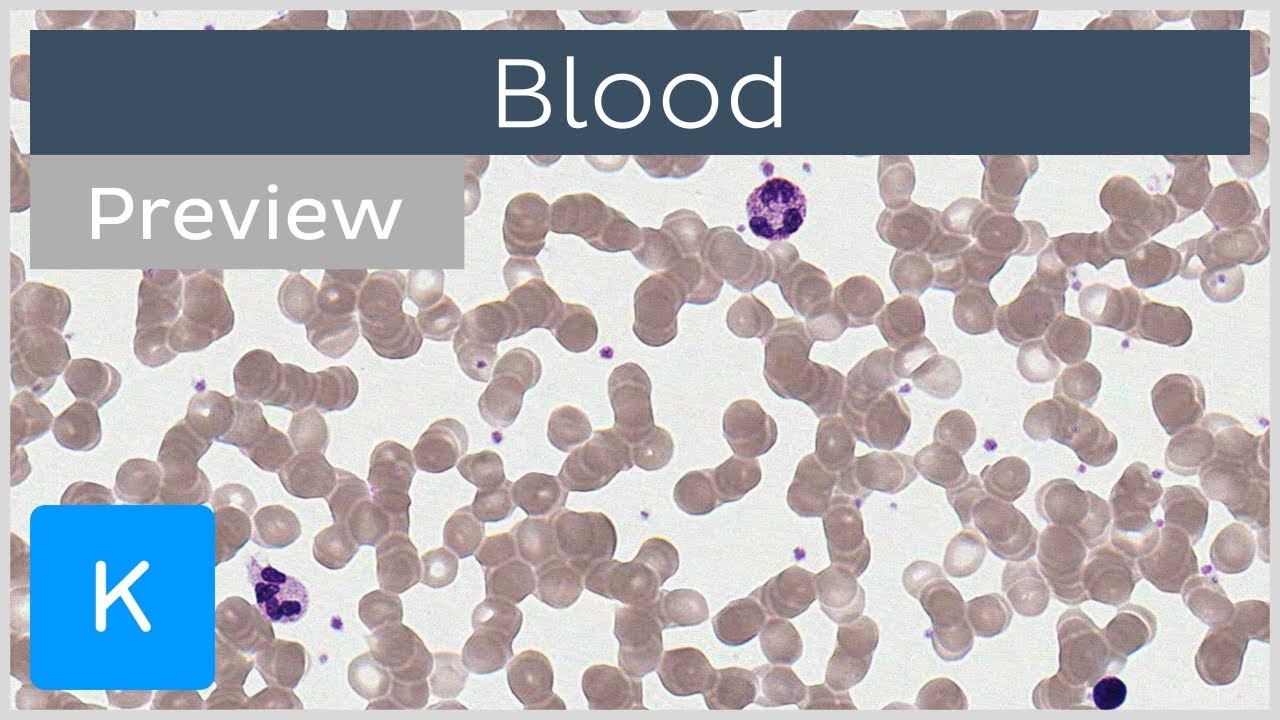

White Blood Cells (WBCs)
Lesson 10 of 16 · Detailed theory + identification points
Points of Identification
5 pointsDetailed Theory
Object: Examination of White Blood Cells (Leukocytes)
General Overview
Leukocytes are nucleated cells essential for immunity. They are classified into granulocytes (neutrophils, eosinophils, basophils) and agranulocytes (lymphocytes, monocytes). On a Romanowsky-stained smear (Wright/Giemsa), each type has distinctive nuclear morphology and cytoplasmic granules.

Granulocytes
| Feature | Neutrophil | Eosinophil | Basophil |
|---|---|---|---|
| Nucleus | 2–5 lobes | Bilobed | Bilobed / S‑shaped |
| Granules | Fine, pink-purple | Coarse, red‑orange | Large, purple‑black |
| Size (µm) | 10–12 | 12–15 | 10–14 |
| % in blood | 40–70% | 1–5% | <1% |
| Main function | Bacterial phagocytosis | Anti‑parasitic, allergy | Hypersensitivity |
Agranulocytes
| Feature | Lymphocyte | Monocyte |
|---|---|---|
| Nucleus | Round, dense chromatin | Kidney‑shaped / indented |
| Cytoplasm | Scant, pale blue rim | Abundant, grey‑blue |
| Size (µm) | 6–15 | 12–20 |
| % in blood | 20–40% | 2–8% |
| Main function | Adaptive immunity | Macrophage/dendritic precursor |
Distinguishing Features on Smear
- Neutrophils – multilobed, most numerous
- Eosinophils – bright red granules, bilobed
- Basophils – dark purple granules, often obscure nucleus
- Lymphocytes – round dark nucleus, thin cytoplasm
- Monocytes – large, indented nucleus, abundant grey cytoplasm
Video Lesson
White Blood Cells (WBCs) — Histology Video Lesson
Click to play video lesson
References
4 sources- 1
Ross MH, Pawlina W. Histology: A Text and Atlas (8th ed.). Wolters Kluwer; 2020.
- 2
Young B, O'Dowd G, Woodford P. Wheater's Functional Histology (6th ed.). Churchill Livingstone/Elsevier; 2014.
- 3
Hoffbrand AV, Moss PAH. Essential Haematology (7th ed.). Wiley-Blackwell; 2016.
- 4
Bain BJ. Blood Cells: A Practical Guide (5th ed.). Wiley-Blackwell; 2015.
Disclaimer: These notes are for educational purposes only and compiled from standard histology textbooks. Clinical interpretation of slides requires a qualified histologist or pathologist.
Ready to test yourself?
Apply what you've learned in the Histology Spotting Test